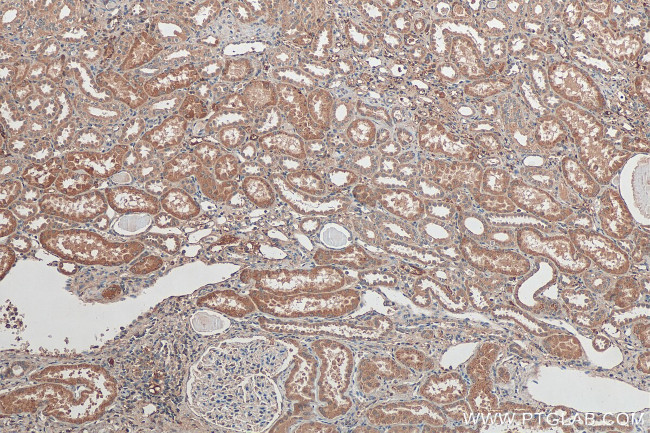
ZDHHC12 Antibody in Immunohistochemistry (Paraffin) (IHC (P))

Search
Proteintech
ZDHHC12 Polyclonal Antibody
{{$productOrderCtrl.translations['antibody.pdp.commerceCard.promotion.promotions']}}
{{$productOrderCtrl.translations['antibody.pdp.commerceCard.promotion.viewpromo']}}
{{$productOrderCtrl.translations['antibody.pdp.commerceCard.promotion.promocode']}}: {{promo.promoCode}} {{promo.promoTitle}} {{promo.promoDescription}}. {{$productOrderCtrl.translations['antibody.pdp.commerceCard.promotion.learnmore']}}
产品信息
26433-1-AP
种属反应
宿主/亚型
分类
类型
抗原
偶联物
形式
浓度
规格
纯化类型
保存液
内含物
保存条件
运输条件
产品详细信息
Immunogen sequence: MAPWALLSP GVLVRTGHTV LTWGITLVLF LHDTDKSADE LLATHSHSWN QHLQAFAQPG THFPTSNCTP TPPTPVLPGP ASLCSPASPE LRQWEEQGEL LLPLTFLLLV LGSLLLYLAV SLMDPGYVNV QPQPQEELKE EQTAMVPPAI PLRRCRYCLV LQPLRARHCR ECRRCVRRYD HHCPWMENCV GERNHPLFVV YLALQLVVLL WGLYLAWSGL RFFQPWGLWL RSSGLLFATF LLLSLFSLVA SLLLVSHLYL VASNTTTWEF ISSHRIAYLR QRPSNPFDRG LTRNLAHFFC GWPSGSWETL WAEEEEEGSS PAV (1-322 aa encoded by BC048251)
靶标信息
ZDHHC12 gene ontology annotations related to this gene include peptidyl-L-cysteine S-palmitoylation; protein palmitoylation; protein targeting to membrane.
仅用于科研。不用于诊断过程。未经明确授权不得转售。
篇参考文献 (0)
生物信息学
蛋白别名: DHHC domain-containing cysteine-rich protein 12; DHHC-12; Palmitoyltransferase ZDHHC12; probable palmitoyltransferase ZDHHC12; unnamed protein product; Zinc finger DHHC domain-containing protein 12; zinc finger DHHC-type containing 12; zinc finger DHHC-type palmitoyltransferase 12; Zinc finger protein 400
基因别名: 1190004A01Rik; DHHC-12; PSEC0008; ZDHHC12; ZNF400
UniProt ID: (Human) Q96GR4, (Mouse) Q8VC90
Entrez Gene ID: (Human) 84885, (Mouse) 66220